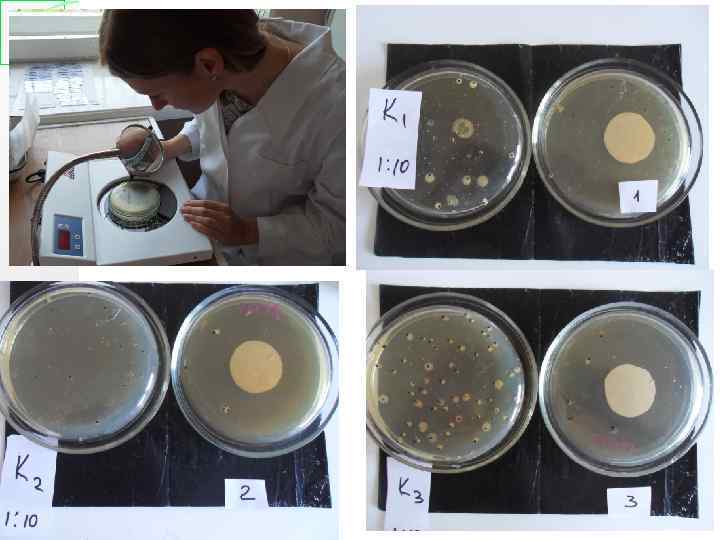
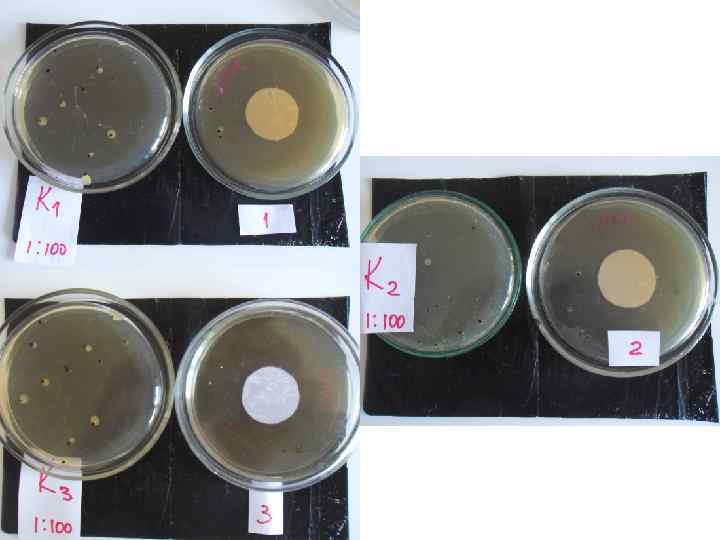
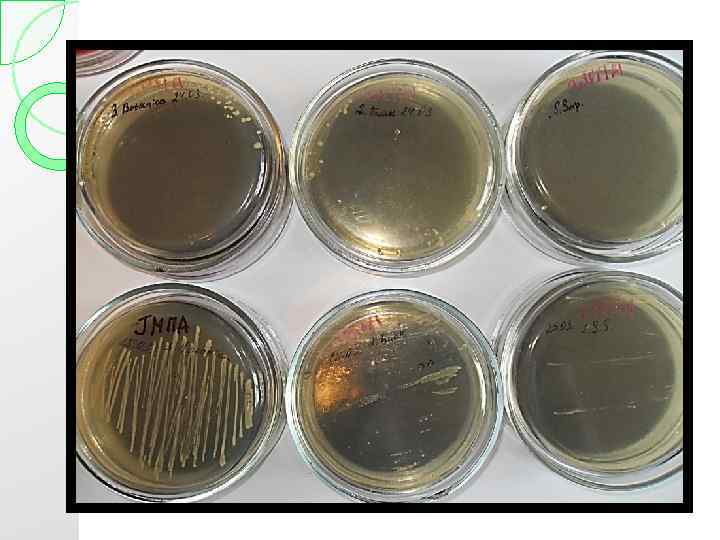

ЭМ Сосны обыкновенной- конференция.pptx
- Количество слайдов: 21

ВЛИЯНИЕ ЭФИРНОГО МАСЛА СОСНЫ ОБЫКНОВЕННОЙ НА МИКРОФЛОРУ КОЖИ РУК Выполнила: Студентка 5 курса, группы А Романова Анастасия Сергеевна Научный руководитель: старший преподаватель, Поворова Оксана Викторовна Могилев 2014 г.

Цель: изучить влияние эфирного масла Сосны обыкновенной на микрофлору кожи человека. Задачи: 1 – сравнить качество масел Сосны обыкновенной, предлагаемых различными производителями; 2 – определить их подлинность и наличие примесей; 3 - проанализировать бактерицидные свойства (бактериостатические) эфирных масел выбранных производителей.

Предмет исследования - свойства эфирного масла; Объект исследования – эфирное масло Сосны обыкновенной. Методы проведения исследования: - путем постановки лабораторного эксперимента, - статистический анализ данных.

Варианты опыта: Определения влияния эфирного масла Сосны обыкновенной на микрофлору кожи рук № масла Наименование выбранной фирмы 1 Концентрация масла на 1 чашку Петри (мл) Количество чашек Петри опытных - конция смывов с поверхности кожи рук Количество чашек Петри контрольных – без масла “Саулес Сапнис” 1 3 – 1: 10, 3 – 1: 100 1 – 1: 10, 1 – 1: 100 2 “Биаск” 1 3 – 1: 10, 3 – 1: 100 1 – 1: 10, 1 – 1: 100 3 “Ботаника” 1 3 – 1: 10, 3 – 1: 100 1 – 1: 10, 1 – 1: 100


Результаты бактериологического исследования смывов рук в разведении 1: 10

Результаты бактериологического исследования смывов рук в разведении 1: 100

Динамика изменения развития колоний под влиянием образцов эфирного масла Сосны обыкновенной (смывы в разведениях 1: 10 и 1: 100) 70 65 60 50 47 40 КОЕ 30 24 20 13 12 10 12 8 3 1. 7 6 1. 7 1. 3 0 Масло № 1 Контроль1 (1: 10) Опыт 1(1: 10) Масло № 2 Контроль2 (1: 100) Опыт2 (1: 100) Масло № 3

Соотношение Г+ микроорганизмов к Г‾ в контрольных чашках по сравнению с опытными чашками (%) 80 71. 4 70 65 65 60 55. 5 50 50 50 44. 5 %40 30 35 35 28. 6 20 10 0 Контроль Препарат № 1 Препарат № 2 Гр+ Гр- Препарат № 3 Опыт

Определение влияния эфирного масла Сосны обыкновенной на Escherichia coli Контрольная чашка. 100% рост на поверхности агара

Определение примесей в эфирном масле Сосны обыкновенной Варианты опыта: 1) Определение примеси этилового спирта 2) Определение примеси жирных и минеральных масел 3) Определение примесей синтетических эфиров щавелевой, янтарной, лимонной, лауриновой, фталевой кислот.




Проверка качества масел Сосны обыкновенной, предлагаемых различными производителями органолептическим методом. Критерии оценки качества Стеклянный флакон с дозатором Флакон темного цвета Продается в отдельной упаковке Полное ботаническое наименования (на латинском языке) Оптимальная расфасовка эфирных масел (не больше 10 мл) Наименование фирмы “Ботаника” “ Биаск ” “Саулес Сапнис” + + + 5 мл 10 мл

Указываются условия + хранения + + Указан регистрационный Номер Наличие инструкции Цвет + + прозрачное с слегка желтоваты м оттенком - + + прозрачное с слегка желтоватым оттенком - Оставляет пятно на листе бумаги Скорость испарения с 30 минут листка бумаги 30 минут 25 минут

Заключение: 1) Все три образца обладают в разной степени бактерицидной активностью: масло под № 3 проявляет самые сильные антисептические свойства, на втором месте по силе стоит масло под № 2 и на третьем месте эфирное масло под № 1. 2) Грам-отрицательные бактерии более устойчивей к бактерицидным свойствам эфирного масла Сосны обыкновенной по сравнению с грам-положительными. 3) В маслах № 1 и № 2 обнаружено присутствие жирных масел, относящихся к классу жиров (базовые масла). В остальных вариантах опыта примеси не обнаружены. 4) Из трех выбранных фирм, масло фирмы «Ботаника» (образец № 3) является наилучшего качества, как по химико-физическим свойствам, так и по бактериостатическим.

ЭМ Сосны обыкновенной- конференция.pptx